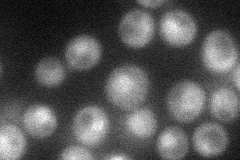
YBL097W

View description
Subunit of the condensin complex; required for chromosome condensation and for clustering of tRNA genes at the nucleolus; may influence multiple aspects of chromosome transmission
Localization:
Intensity:
Fold change:
Significance:
-
C’ GFP library in SD

nucleus23.72 -
N' NOP1pr-GFP in SD
cytosol,punctate,nucleus35.6524 -
N' TEF2pr-mCherry in SD

nucleus17.3886 -
N' NATIVEpr-GFP in SD

punctate,nucleus24.6047 -
N' TEF2pr-VC and Cyto-VN in SD

below threshold27.0931 -
C’ GFP library in SD+DTT

nucleus, punctate25.541.07No -
C’ GFP library in SD+H2O2

nucleus28.151.18No -
C’ GFP library in Starvation Media

nucleus, punctateN/AN/AYes -
C’ GFP library on the background of Pup2-DaMP

nucleus -
C’ GFP library on the background of CCT mutant

nucleus24.12031.01661No
